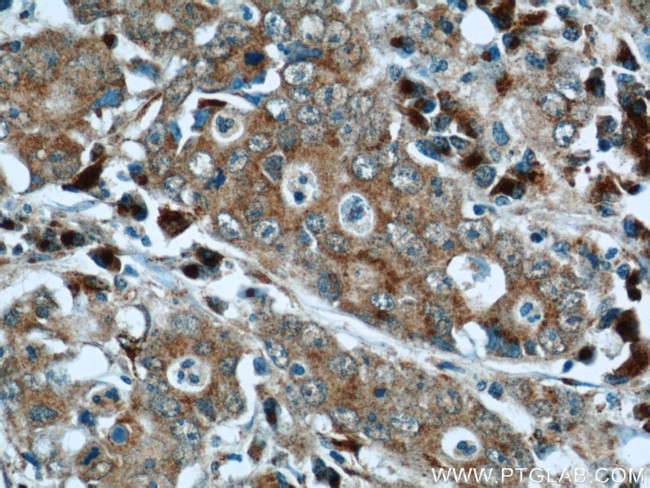
FAM3C Antibody in Immunohistochemistry (Paraffin) (IHC (P))

Search
Proteintech
FAM3C Polyclonal Antibody
{{$productOrderCtrl.translations['antibody.pdp.commerceCard.promotion.promotions']}}
{{$productOrderCtrl.translations['antibody.pdp.commerceCard.promotion.viewpromo']}}
{{$productOrderCtrl.translations['antibody.pdp.commerceCard.promotion.promocode']}}: {{promo.promoCode}} {{promo.promoTitle}} {{promo.promoDescription}}. {{$productOrderCtrl.translations['antibody.pdp.commerceCard.promotion.learnmore']}}
产品信息
14247-1-AP
种属反应
已发表种属
宿主/亚型
分类
类型
抗原
偶联物
形式
浓度
规格
纯化类型
保存液
内含物
保存条件
运输条件
产品详细信息
Immunogen sequence: KMDASLGNL FARSALDTAA RSTKPPRYKC GISKACPEKH FAFKMASGAA NVVGPKICLE DNVLMSGVKN NVGRGINVAL ANGKTGEVLD TKYFDMWGGD VAPFIEFLKA IQDGTIVLMG TYDDGATKLN DEARRLIADL GSTSITNLGF RDNWVFCGGK GIKTKSPFEQ HIKNNKDTNK YEGWPEVVEM EGCIPQKQD (30-227 aa encoded by BC046932)
靶标信息
FAM3C is a 227 amino acid secretory protein that belongs to a novel cytokine-like family with sequence similarity to FAM3 family. FAM3C is a signaling cytokine with a GG domain, hydrophobic leader sequence and an N-terminal signal peptide. FAM3C has a cytokine activity and shows a change in expression in pancreatic cancer-derived cells. It is ubiquitously expressed in most of the tissues. Reports suggest that FAM3C plays an important role in inner ear development and may thus be involved in cell differentiation and proliferation during inner ear embryogenesis.
仅用于科研。不用于诊断过程。未经明确授权不得转售。
生物信息学
蛋白别名: family with sequence similarity 3 member C; Interleukin-like EMT inducer; interleukin-like epithelial-mesenchymal transition inducer; predicted osteoblast protein; Protein FAM3C; unnamed protein product
基因别名: FAM3C; GS3786; ILEI
UniProt ID: (Human) Q92520
Entrez Gene ID: (Human) 10447